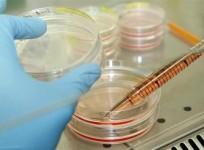

2015 Budget


Interim Budget 2019: Farm, telecom sectors may see major relief proposals

Budget 2016-17: Where to watch live whether Arun Jaitley will raise tax exemption limit

Budget 2016: Twitterati vote for farmers, Make in India in finance ministry's Twitter poll

Modi Hopes for Productive Budget Session Filled with Constructive Debates

Government Inks Monetary Policy Deal with RBI on Inflation Control

Union Budget 2015: 'India is about to take off,' Says Jaitley Delivering His Maiden Full-Year Budget Focused On Growth

Budget 2015: BJP Leaders Full of Praise for Arun Jaitley

Wealth Tax Abolished; Super Rich Taxed 2%
Atal Innovation Mission: ₹150 crore for Research and Innovation

Five Mega Power Projects of 4,000 MWs each to be Set up

India Budget 2015: Gold Monetisation Scheme in the Works

Tax Deductible Investments Hiked to ₹4.4 lakh

Union Budget 2015: Black Money Law Violation to Attract Rigorous Imprisonment of up to 10 Yrs

Union Budget 2015: Excise Duty on Cigarettes go up, Tobacco Company Stocks Slip
Advertisement
Advertisement